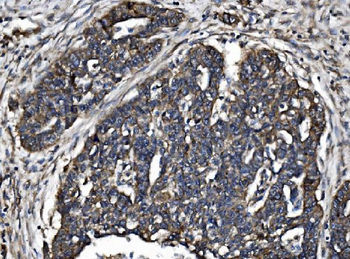
TJP2/ZO2 Antibody

You have no items in your shopping cart.
- KHSRP Antibody [orb763126]
ELISA, FC, ICC, IF, IHC, IP, WB
Human, Rat
Rabbit
Polyclonal
Unconjugated
100 μg - CD3 epsilon/CD3E Antibody [orb196263]
ICC, IF, IHC, IHC-Fr, WB
Gallus, Human, Mouse, Rat
Rabbit
Polyclonal
Unconjugated
100 μg - HP1 alpha/CBX5 Antibody [orb654408]
ELISA, FC, ICC, IF, IHC, WB
Human, Mouse, Rat
Rabbit
Polyclonal
Unconjugated
100 μg - non-muscle Myosin IIB/MYH10 Antibody [orb654443]
FC, ICC, IF, IHC, WB
Human, Mouse, Rat
Rabbit
Polyclonal
Unconjugated
100 μg - CD3 Intracellular domain Antibody [orb1294242]
IF, IHC, WB
Human, Mouse, Rat
Rabbit
Polyclonal
Unconjugated
25 μl, 100 μl - Aconitase 1/ACO1 Antibody [orb654400]
ELISA, FC, ICC, IF, IHC, WB
Human, Monkey, Mouse, Rat
Rabbit
Polyclonal
Unconjugated
100 μg - TJP2/ZO2 Antibody [orb745930]
FC, ICC, IF, IHC, WB
Human, Monkey, Mouse, Rat
Rabbit
Polyclonal
Unconjugated
100 μg





























































![Anti-CD3 epsilon [YTH 12.5]](/images/pub/media/catalog/product/NewWebsite/35/orb411552_1.png)
![Anti-CD3 epsilon [YTH 12.5]](/images/pub/media/catalog/product/NewWebsite/35/orb411552_2.png)
![Anti-CD3 epsilon [YTH 12.5]](/images/pub/media/catalog/product/NewWebsite/35/orb411552_3.png)
![Anti-CD3 epsilon [YTH 12.5]](/images/pub/media/catalog/product/NewWebsite/35/orb411552_4.png)
![Anti-CD3 epsilon [YTH 12.5]](/images/pub/media/catalog/product/NewWebsite/35/orb411552_5.png)